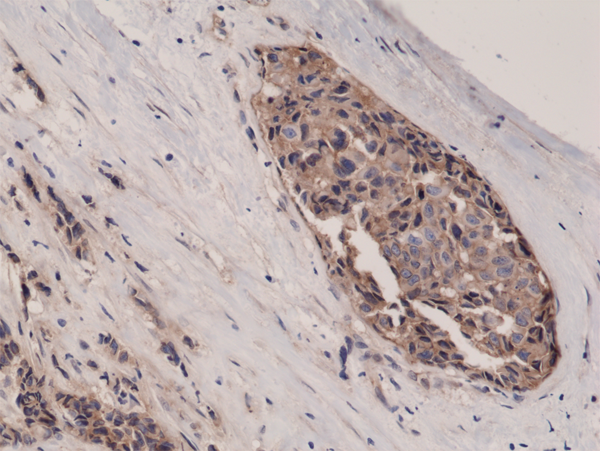

Recombinant Rabbit Monoclonal Antibody to Beta-Catenin 1 (CTNNB1) (Clone: RM276)(Discontinued)
Figure 1: Western Blot of HeLa and 293 cells lysates using Anti- Beta -Catenin Rabbit Monoclonal Antibody (Clone: RM276) at a 1:400 dilution.
Roll over image to zoom in
Shipping Info:
For estimated delivery dates, please contact us at [email protected]
| Format : | Purified |
| Amount : | 100 µl |
| Isotype : | Rabbit IgG |
| Purification : | Protein A affinity purified from an animal origin-free culture supernatant |
| Content : | Antibody in 50% Glycerol/PBS with 1% BSA and 0.09% sodium azide |
| Storage condition : | Store at -20°C. Avoid repeated freeze and thaw cycles. |
Clone RM276 reacts to human Beta-Catenin (Catenin beta-1). This antibody may also react to mouse or rat Beta-Catenin, as predicted by immunogen homology. Immunohistochemistry (IHC): 1:500-1:1000 dilution; Western Blot (WB): 1:400-1:1000 dilution.
For Research Use Only. Not for use in diagnostic/therapeutics procedures.
| Subcellular location: | Cytoplasm, Nucleus, Cytoplasm, Cell junction, Cell junction, Cell membrane, Cytoplasm, Cytoplasm, Cell junction, Cytoplasm |
| Post transnational modification: | Deacetylated at Lys-49 by SIRT1. |
| Tissue Specificity: | Expressed in several hair follicle cell types: basal and peripheral matrix cells, and cells of the outer and inner root sheaths. Expressed in colon. Present in cortical neurons (at protein level). Expressed in breast cancer tissues (at protein level) (PubMed:29367600). |
| BioGrid: | 107880. 630 interactions. |
|
There are currently no product reviews
|

.png)











